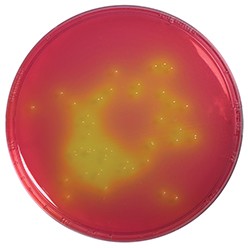
محیط کشت منیتول سالت آگار

وضعیت موجودی
محصولات موجود
دسته بندی
ثبت امتیاز